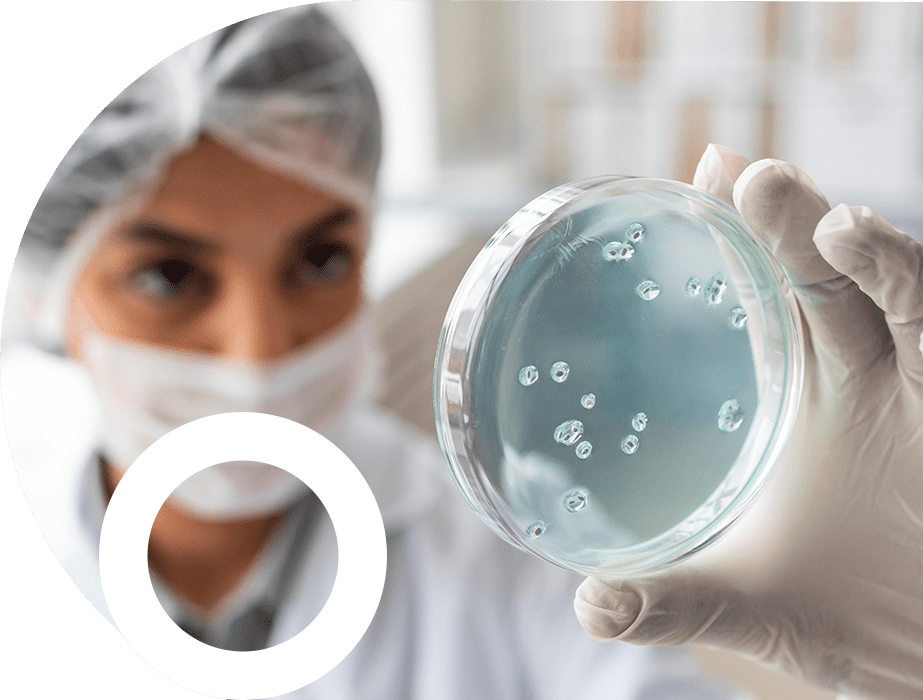

Miembros Académicos


Dr. Pablo González Muñoz
IMII, UC
RUT:
Unidad Académica: Pontificia Universidad Católica de Chile
Cargo: Profesor Asociado Departamento de Genética Molecular y Microbiología, Investigador Asociado, Instituto Milenio en Inmunología e Inmunoterapia, Facultad de Ciencias Biológicas, Pontificia Universidad Católica de Chile
Departamento: Departamento de Genética Molecular y Microbiología
Facultad: Facultad de Ciencias Biológicas
Bioquímico UC, Doctor en Genética Molecular y Microbiología UC.
El interés principal de mi laboratorio de investigación es identificar, caracterizar y modular determinantes moleculares del hospedero y del virus que impacten la infección y ciclo replicativo de virus persistentes. Estoy particularmente interesado en el estudio de virus de la familia herpes, específicamente aquellos que afectan piel, ojo, mucosas y cerebro, como los virus herpes simple de tipo 1 y de tipo 2 (HSV-1 y HSV-2). La investigación realizada en mi laboratorio se relaciona con la virología e inmunología y hace uso de cultivos celulares para estudios in vitro y modelos murinos para estudiar la infección por HSV in vivo. Las preguntas principales de investigación en mi laboratorio son:
- A. ¿Qué factores del hospedero modulan la replicación de HSV? ¿Cómo impactan el ciclo infectivo de virus herpes simple factores celulares involucrados en la respuesta a proteínas mal plegadas (UPR), el metabolismo de lípidos y la respuesta a estrés oxidativo, entre otros? ¿Pueden modularse farmacológicamente estos factores para alterar la replicación de estos virus?
- B. ¿Cual es el rol de células inmunes en etapas tempranas de infección por HSV y cómo impacta esta infección el establecimiento de inmunidad antiviral a largo plazo?
- C. ¿Existen botánicos o compuestos con indicación de uso distinto a antiviral que tengan actividad contra virus herpes simple? Estamos interesados en identificar nuevos antivirales de origen natural con actividad anti-herpética, así como drogas existentes con potenciales nuevos usos antivirales.
- D. ¿Qué rol juega la infección latente y asintomática del cerebro con HSV-1 en la susceptibilidad de los individuos de sufrir enfermedades autoinmunes del sistema nervioso central? Estamos interesados en estudiar los procesos inflamatorios que induce la infección latente del cerebro con HSV-1 y cómo esto repercute en la tolerancia de este tejido por parte del sistema inmune.
Contacto
Teléfono: +56226862667; +56 226862842
Publicaciones Seleccionadas